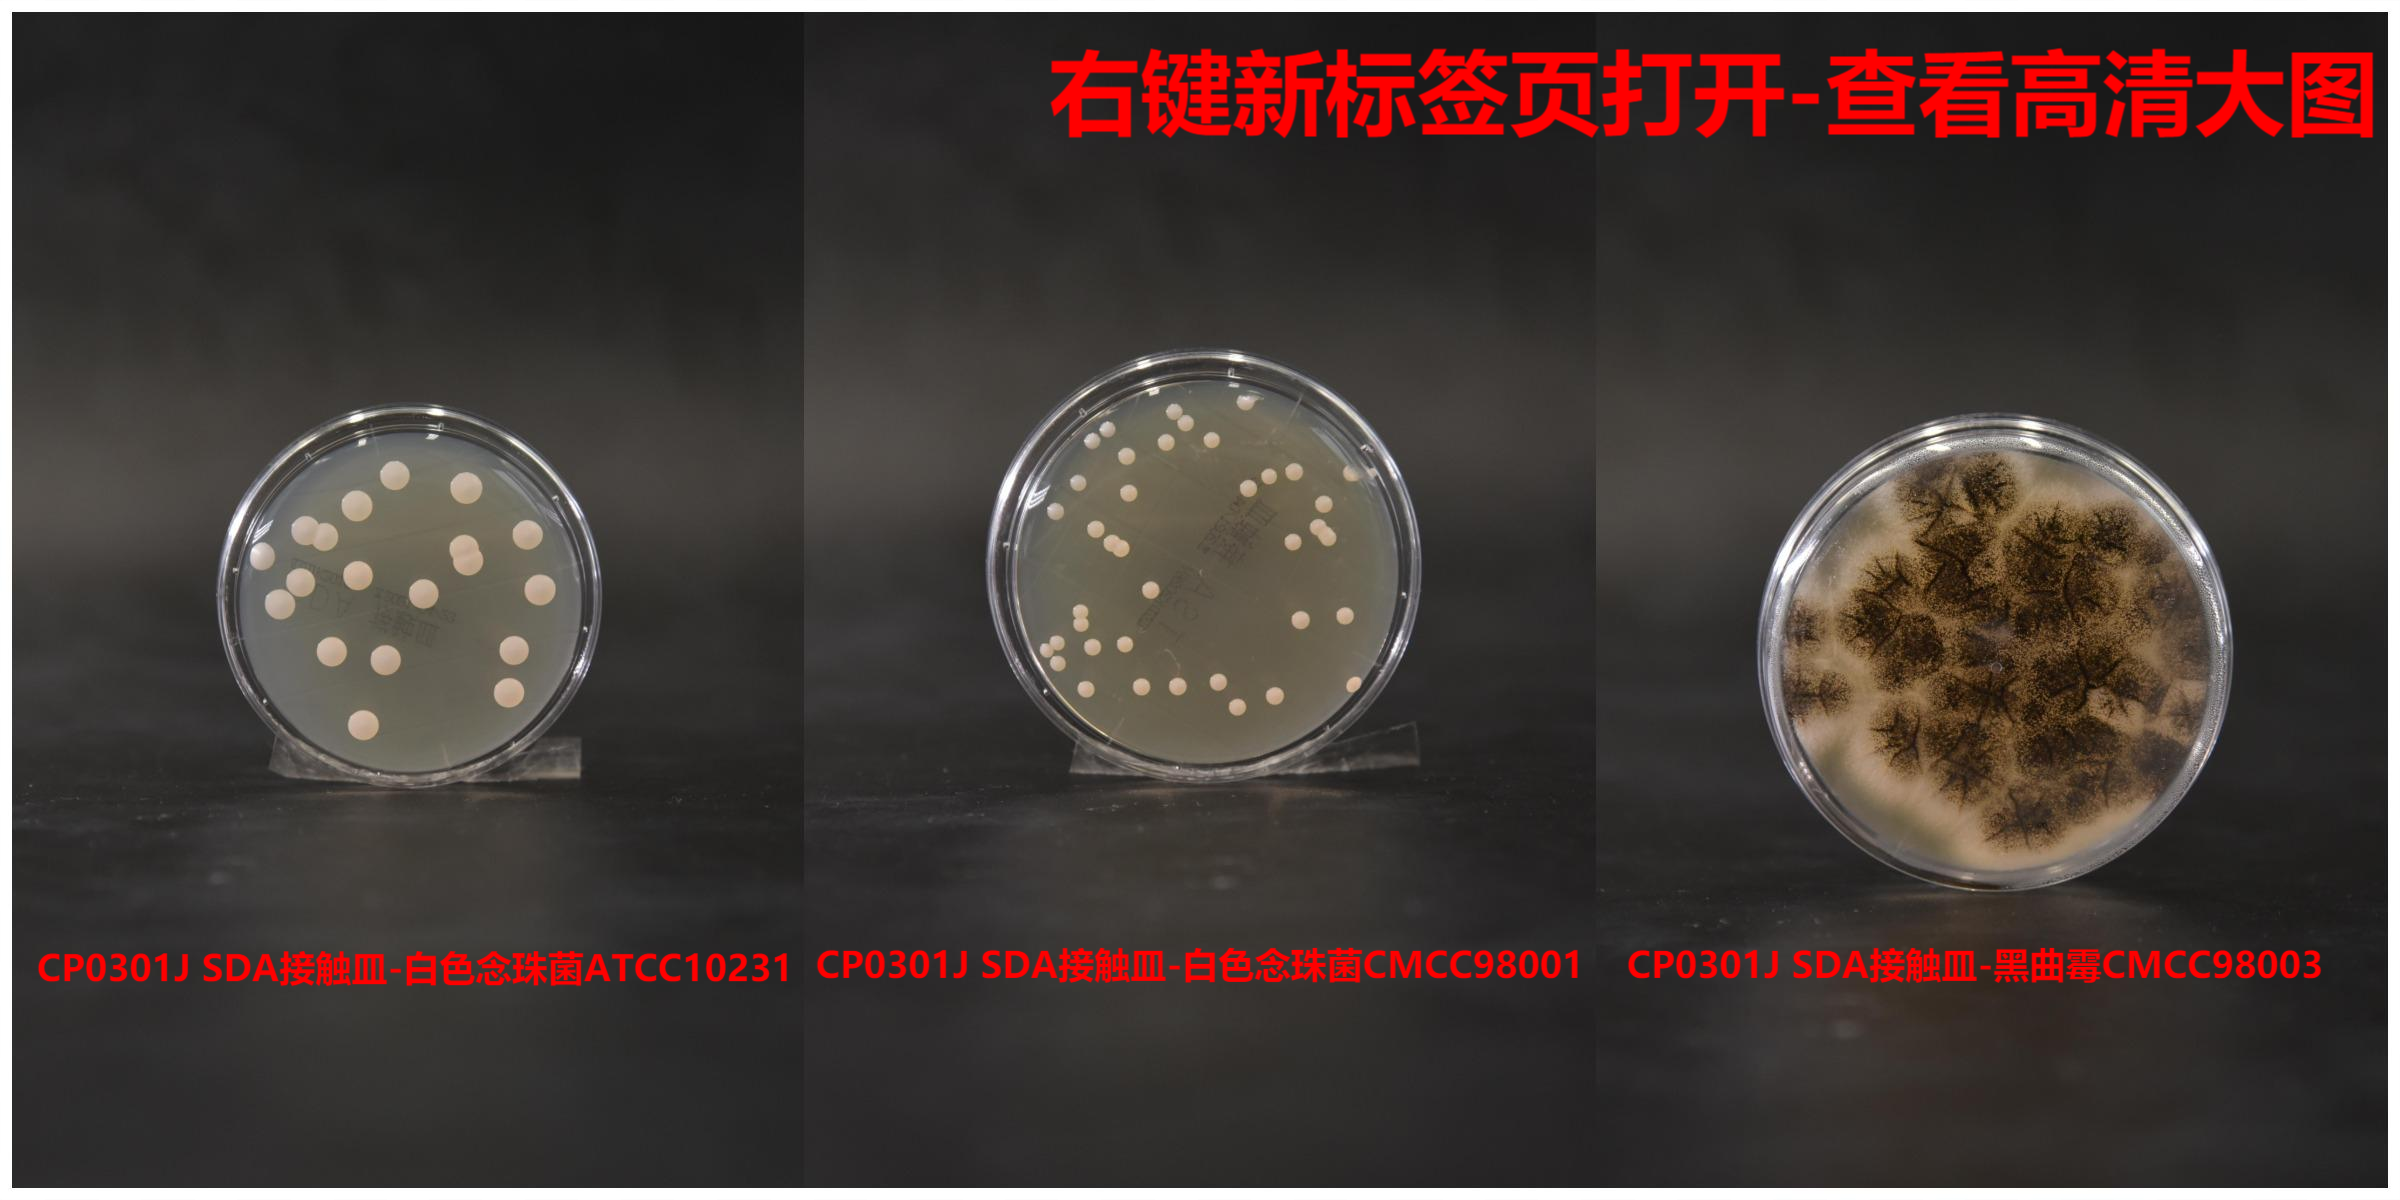
SDA接触皿(药典)(三层无菌包装) 55mm

相关产品推荐更多 >
万千商家帮你免费找货
0 人在求购买到急需产品
- 详细信息
- 技术资料
- 库存:
9999
- 英文名:
SDA Contact Plate IRRAD with 3 WRAP
- 保质期:
见产品包装
- 供应商:
广东环凯
- 保存条件:
2~25℃,避光保存
- 规格:
55mm×10个/包
产品名称:SDA接触皿(三层无菌包装)
英文名称:SDA Contact Plates RRAD with 3 WRAP
其它叫法:沙氏葡萄糖琼脂培养基平板 | 沙氏葡萄糖琼脂接触皿平板
产品编号与包装规格:
| 产品编号 | 产品类型 | 包装规格 |
| CP0301J | 即用型成品 | 55mm×10个/包 |
产品用途:用于空间环境中浮游菌及沉降菌等微生物的测定以及实验室相关微生物指标的测定。
SDA接触皿检验原理:葡萄糖提供碳源;酪蛋白胰酶消化物、动物组织的胃酶消化物等量混合提供氮源;琼脂是凝固剂。
配方成分:
| 配方(每升) | 含量 |
| 葡萄糖 | 40.0g |
| 酪蛋白胰酶消化物、动物组织的胃酶消化物等量混合 | 10.0g |
| 琼脂 | 15.0g |
| 纯化水 | 1000mL |
| 最终pH 5.6±0.2 | |
使用方法:
1、 从储藏室(2-25℃)取出接触皿,并恢复至室温。
2、 将包装整体送入取样地点,在此过程中逐步去掉外面两层包装,最后一层包装在操作间打开。
3、 打开接触皿上盖,使培养基表面与取样面直接接触,均匀按压接触皿底板,确保全部琼脂表面与取样点表面均匀接触10s左右,再盖上皿盖。
4、 在接触皿磨砂区域标记取样地点、取样时间和取样人。
5、 用消毒剂或杀孢子剂擦拭测试区域,以消除培养基的残留。
6、 将接触皿从洁净室取出,置于培养箱中按规定的温度和时间培养。
7、 培养结束后,从培养箱中取出观察、计数。



质量控制:
1、感官、理化指标:淡黄色透明、清晰无沉淀,表面平整、无裂痕、无肉眼可见杂质和气泡,平皿的琼脂层厚度为4.5-5.5mm,pH值为5.6士0.2。
2、生物学指标:下列质控菌株接种待测试培养基,如下:
| 指标 | 质控菌株及编号 | 培养条件 | 特征性反应 |
| 生长率 | 白色念珠菌CMCC98001 | 20~25℃,48~72h | PR:0.5~2.0,乳白色菌落 |
| 黑曲霉CMCC98003 | PR:0.5~2.0,白色菌丝,孢子黑色 |
3、无菌及持水性实验:30-35℃培养7天,无菌落生长,无脱水收缩。
储存条件与保质期:2~25℃,避光保存;有效期见包装。
注意事项:产品多次在低温与常温之间变更会引起琼脂的泌水,属于正常现象。使用前 应平衡至室温且尽量在无菌干燥箱中预干燥。
参考文献:《中华人民共和国药典》2020年版、美国药典、欧洲药典
SDA接触皿 相关表面、沉降菌、浮游菌检测三层包装无菌平板培养基产品目录 :
| 编号 | 产品名称 | 规格 | 用途 |
| CP0201C | TSA平皿(三层无菌包装) | 90mm×10个平板 | 用于食品医药工业洁净区沉降菌、浮游菌检测和压缩空气微生物检测 |
| CP0301C | SDA平皿(三层无菌包装) | 90mm×10个平板 | |
| CP0101C | NA平皿(三层无菌包装) | 90mm×10个平板 | |
| CP0204C | TSAWLP平皿 (TSA+卵磷脂+吐温80) |
90mm×10个平板 | 用于化学消毒后环境空气微生物监测 |
| CP0205C | TSAWLPZS平皿 (TSA+卵磷脂+吐温80+组氨酸+硫代硫酸钠) |
90mm×10个平板 | |
| CP202C | TSAC平皿(TSA+头孢菌素酶) | 90mm×10个平板 | 用于头孢类抗生素残留的环境微生物监测 |
| CP203C | TSAP平皿(TSA+青霉素酶) | 90mm×10个平板 | 用于青霉素类抗生素残留的环境微生物监测 |
| CP0201J | TSA接触皿(三层无菌包装) | 55mm×10个平板 | 用于食品医药工业洁净区表面微生物检测 |
| CP0101J | NA接触皿(三层无菌包装) | 55mm×10个平板 | |
| CP0204J | TSAWLP接触皿 (TSA+卵磷脂+吐温80) |
55mm×10个平板 | 用于化学消毒后物体表面微生物监测 |
| CP0205J | TSAWLPZS接触皿 (TSA+卵磷脂+吐温80+组氨酸+硫代硫酸钠) |
55mm×10个平板 | |
| CP202J | TSAC接触皿(TSA+头孢菌素酶) | 55mm×10个平板 | 用于头孢类抗生素残留的环境物体表面微生物监测 |
| CP203J | TSAP接触皿(TSA+青霉素酶) | 55mm×10个平板 | 用于青霉素类抗生素残留的环境物体表面微生物监测 |

风险提示:丁香通仅作为第三方平台,为商家信息发布提供平台空间。用户咨询产品时请注意保护个人信息及财产安全,合理判断,谨慎选购商品,商家和用户对交易行为负责。对于医疗器械类产品,请先查证核实企业经营资质和医疗器械产品注册证情况。
 技术资料
技术资料









